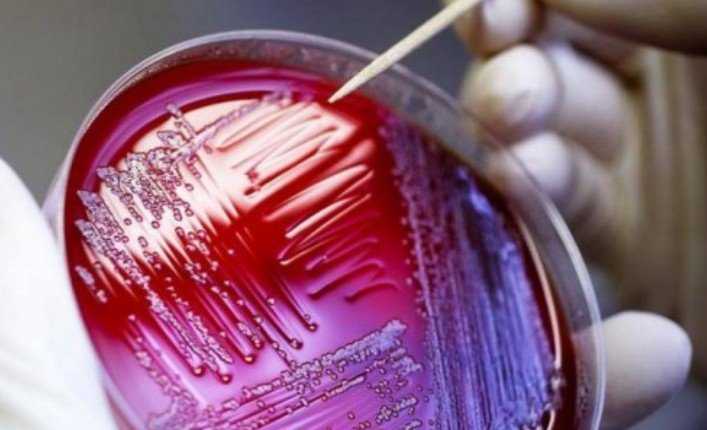

Ένα “ζωντανό φάρμακο” από γενετικώς τροποποιημένα ζωύφια έχει παρατείνει τη ζωή ζώων με σοβαρή μεταβολική νόσο, σε μια κλινική δοκιμή – ορόσημο.
Οι ερευνητές δημιούργησαν το φάρμακο, κάνοντας ένα κοινό στέλεχος βακτηριδίων (E coli) να “σκουπίσει” την περίσσεια αμμωνίας στο σώμα. Τα υψηλά επίπεδα αμωνίας μπορεί να είναι θανατηφόρα για τα άτομα με ηπατική βλάβη και με σπάνιες γενετικές διαταραχές.
Οι δοκιμές έδειξαν ότι τα μικρόβια μείωσαν τα επικίνδυνα επίπεδα αμμωνίας και αύξησαν τα ποσοστά επιβίωσης σε ευαίσθητα ποντίκια, ενώ μια μικρή δοκιμή σε 52 υγιείς ανθρώπους βρήκε ότι τα βακτηρίδια λειτούργησαν όπως αναμενόταν και ήταν ασφαλή.
Η ανακάλυψη χαρακτηρίστηκε ως “εκπληκτική” από κορυφαίους επιστήμονες, που είπαν ότι τέτοια φάρμακα ανήκαν στη σφαίρα της φαντασίας μέχρι πριν από λίγα χρόνια.
“Με τη δημιουργία αυτών των βακτηριδίων είμαστε σε θέση να ελέγξουμε πώς λειτουργούν στον γαστρεντερικό σωλήνα του ανθρώπου”, δήλωσε η Caroline Kurtz. “Μας επιτρέπει να σκεφτόμαστε πολλές άλλες ασθένειες, για τις οποίες μπορεί να χρειαστεί να παραγάγουμε κάτι ωφέλιμο ή να αφαιρέσουμε κάτι τοξικό για τον ασθενή”.
Οι επιστήμονες επικεντρώθηκαν σε μια διαταραχή, που ονομάζεται υπεραμμωνιαιμία. Εμφανίζεται όταν τα επίπεδα της τοξικής αμμωνίας συσσωρεύονται στο αίμα και επηρεάζουν τον εγκέφαλο. Σε ήπιες περιπτώσεις, οι άνθρωποι αισθάνονται άρρωστοι, χάνουν την όρεξή τους, αλλά σε σοβαρές περιπτώσεις προκαλείται μη αναστρέψιμη και μερικές φορές θανατηφόρα εγκεφαλική βλάβη.
Οι περισσότεροι άνθρωποι, που υποβάλλονται σε θεραπεία για υπεραμμωνιαιμία, έχουν ηπατική βλάβη, που εμποδίζει το όργανο να μετατρέψει την αμμωνία στο αίμα σε ουρία. Αλλά η κατάσταση επηρεάζει επίσης εκείνους με σπάνιες γενετικές διαταραχές, που επηρεάζουν την ικανότητα του ήπατος να επεξεργάζεται την αμμωνία. Περίπου η μισή αμμωνία, από αυτή που κυκλοφορεί στο σώμα, θεωρείται ότι προέρχεται από ζωύφια στο έντερο.
Όπως αναφέρεται χαρακτηριστικά στο περιοδικό Science Translational Medicine, οι άνθρωποι λαμβάνουν το E coli ως προβιοτικό για πάνω από έναν αιώνα. Στο έντερο το E coli μετατρέπει την αμμωνία σε αργινίνη, ένα αμινοξύ που μπορεί να μειώσει την αρτηριακή πίεση.
Οι ερευνητές παρενέβησαν στα γονίδια των ζωυφίων και όταν εκείνα έφτασαν στα έντερα, κατανάλωσαν πολύ περισσότερη αμμωνία από το συνηθισμένο. Στη συνέχεια έδωσαν τα τροποποιημένα ζωύφια στα ποντίκια και ενώ όλα τα μη θεραπευμένα ποντίκια πέθαναν μέσα σε μια εβδομάδα, τα μισά από αυτά, που έλαβαν τροποποιημένα μικρόβια μέσω των ζωυφίων, ήταν ακόμη ζωντανά 10 ημέρες αργότερα.